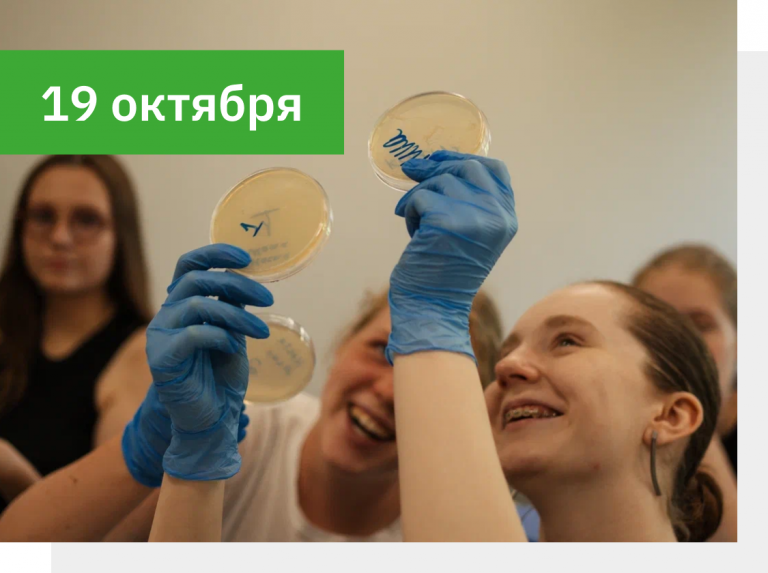

Образовательные мероприятия
События для всех, кто хочет узнать больше о любимом предмете
Лекции, фестивали, вебинары и экскурсии для школьников, их родителей и учителей
Образовательные мероприятия ЦПМ — это бесплатные события для всех, кто хочет узнать больше о любимом предмете, познакомиться с ЦПМ и погрузиться в увлекательный мир олимпиад. Организаторы — наши олимпиадные тренеры и преподаватели, которые готовы заряжать любовью к своему предмету

Как проходят наши мероприятия
13 сентября участвуйте
в V Фестивале языков стран Европы и Азии
Календарь

Вебинар-разбор пробного муниципального этапа ВсОШ по обществознанию
12 октября в 18:00
Предмет: Обществознание
Формат: онлайн
В ходе разбора участники познакомятся с форматом муниципального этапа ВсОШ по обществознанию и проработают подходы к решению типовых заданий.

Научный фестиваль в школе № 1002
16 октября в 15:30
Предмет: Межпредметные
Формат: очно
Главная цель каждого фестиваля — доказать, что наука может быть интересной, и сформировать активное сообщество будущих учёных.

Вебинар «Полезные интернет-ресурсы для подготовки к олимпиадам по праву»
17 октября в 18:00
Предмет: Право
Формат: онлайн
Мы познакомим участников со всем множеством интернет-источников для подготовки и поможем в них разобраться.

Конкурс «История на карте — V»
18 октября с 9:00
Предмет: География, История
Формат: онлайн
За 2,5 часа участникам нужно будет выполнить тестовые и творческие задания, связанные с географией различных процессов в истории.

Географический квест «GeoСuesta»
18 октября с 09:15
Предмет: География
Формат: очно
«GeoСuesta» — это подготовка к географическим олимпиадам и возможность провести свой день весело, интересно и полезно.

Вебинар «Высшая проба по истории искусств— 2025/26: как готовиться?»
18 октября в 18:00
Предмет: Искусство (МХК)
Формат: онлайн
Вебинар проведёт Сергей Медакин, один из организаторов олимпиады, а ведущим выступит тренер сборной Москвы по искусству Серафим Рылов.
Открытый вебинар «Неорганика в цифрах: секреты решения расчётных задач» по химии
19 октября в 16:00
Предмет: Химия
Формат: онлайн
Всем зарегистрированным участникам мы отправим не только записи занятий, но и полезные авторские материалы!

Обществоведческий киноклуб: как фильмы помогают готовиться к олимпиадам по обществознанию
19 октября в 19:00
Предмет: Обществознание
Формат: онлайн
В нашем киноклубе могут участвовать школьники 7–11 классов, интересующиеся обществознанием. Чтобы принять активное участие в обсуждении фильма, рекомендуем посмотреть его заранее.

Научный фестиваль в школе № 1560
21 октября в 15:30
Предмет: Межпредметные
Формат: очно
Главная цель каждого фестиваля — доказать, что наука может быть интересной, и сформировать активное сообщество будущих учёных.

Вебинар «Все об олимпиадах по биологии: какие они бывают, чем отличаются и как использовать их при поступлении?»
22 октября в 17:00
Предмет: Биология
Формат: онлайн
На вебинаре вы узнаете, какими бывают олимпиады, как устроены этапы, какие льготы они дают при поступлении и как разработать стратегию подготовки.

Научный фестиваль в школе № 654
23 октября в 15:30
Предмет: Межпредметные
Формат: очно
Главная цель каждого фестиваля — доказать, что наука может быть интересной, и сформировать активное сообщество будущих учёных.

Вебинар «Как решать задачи в олимпиадах по праву»
29 октября в 19:00
Предмет: Право
Формат: онлайн
Как не терять баллы, зная верный ответ? Как набирать баллы, не зная ответа? Как зацепить любого проверяющего своим ответом? Всё это можно узнать на нашем вебинаре.

Онлайн-практикум к муниципальному этапу ВсОШ по праву
9 ноября в 10:00
Предмет: Право
Формат: онлайн
Участники смогут в поучаствовать в решении задач муниципальных этапов ВсОШ прошлых лет и детально разобрать их решение с преподавателем.

Научный фестиваль в школе № 1580
11 ноября в 15:30
Предмет: Межпредметные
Формат: очно
Главная цель каждого фестиваля — доказать, что наука может быть интересной, и сформировать активное сообщество будущих учёных.

Открытый вебинар «Историческое эссе»
14 ноября в 18:00
Предмет: История
Формат: онлайн
Все участники вебинара получат материал об основах написания исторического эссе, который будет полезен при подготовке к олимпиадам.

Открытый вебинар «Цвета, свойства и применение: как извлечь всю информацию из качественных неорганических задач» по химии
16 ноября в 16:00
Предмет: Химия
Формат: онлайн
Вы узнаете, как применять приведённую в условии качественную информацию о веществах и научитесь использовать знания об их цветах и свойствах.

Лекция-семинар «Откуда произошло государство и право? Чем отличается право разных государств сегодня?»
26 ноября в 19:00
Предмет: Право
Формат: онлайн
На лекции мы детально разберём происхождение государства и права, правовые системы современности и систему права и законодательства.

Осенний турнир юных математиков
29 ноября в 10:00
Предмет: Математика
Формат: онлйан
Турнир поможет проверить свои знания, получить вдохновение и зарядиться мотивацией на весь учебный год.

Конкурс исторических эссе «Под пером историка»
с 9:00 29 ноября до 23:59 30 ноября
Предмет: История
Формат: онлайн
Прекрасная возможность попрактиковаться в решении заданий подобного типа, поработать с нестандартными формулировками тем и получить обратную связь.
Прошедшие мероприятия

Открытый вебинар «Карты на олимпиадах по истории»
10 октября в 18:00
Предмет: География, История
Формат: онлайн
Мы поговорим о том, как эффективно работать с контурными и историческими картами, разберём ключевые моменты, трудности и полезные приёмы.

День астрономии
5 октября с 12:00
Предмет: Астрономия, Физика
Формат: очно
На мероприятии пройдут лекции от учёных и национальных тренеров сборной России по астрономии и астрофизике.

Вебинар «Карл Брюллов: биография и творчество. Что нужно знать для МОШ?»
4 октября в 17:00
Предмет: Искусство (МХК)
Формат: онлайн
Вы узнаете о путешествиях художника, об истории создания и гастролях «Последнего дня Помпеи» и многое другое.

Вебинар «Как выстроить траекторию подготовки к олимпиадам по праву»
1 октября в 19:00
Предмет: Право
Формат: онлайн
Обсудим способы и секреты подготовки, организуем краткий обзор перечневых олимпиад, дадим пояснения к типовым заданиям.

Открытые лекции для подготовки к школьному этапу ВсОШ
С 30 сентября по 3 октября в 17:30
Предмет: География
Формат: онлайн
Открытые лекции проведут преподаватели кафедры, которые подготовили уже не одного дипломанта заключительного этапа.

Открытый вебинар «Тайны атомного мира: радиоактивность в олимпиадной химии»
28 сентября в 16:00
Предмет: Химия
Формат: онлайн
Всем зарегистрированным участникам мы отправим запись вебинара и полезные авторские материалы.

Экскурсия «Несостоявшееся будущее: утопия экспериментального района» в Северном Чертанове
28 сентября в 12:00
Предмет: Искусство (МХК)
Формат: очно
На экскурсии мы расскажем, о чём мечтали советские архитекторы и как утопический проект столкнулся с менее утопичной реальностью.

Экскурсия «Цитадель Москва: фортификация средневековой столицы»
13 сентября в 12:00
Предмет: История
Формат: очно
Ребята узнают о том, как развивались крепостные сооружения в средневековой Москве, как постепенно менялось их значение.

V Фестиваль языков стран Европы и Азии
13 сентября с 10:00
Предмет: Арабский язык, Испанский язык, Итальянский язык, Китайский язык
Формат: очно
В 2025 году основной темой мероприятия станет межкультурный диалог России и стран Азии и Африки.

Вебинар «Олимпиада по ОБЗР: секретный путь к победе»
10 сентября в 17:00
Предмет: ОБЗР
Формат: онлайн
Мероприятие проведёт Екатерина Терешенкова, трёхкратный призёр заключительного этапа ВсОШ, победительница и призёр соревнований «Первенство по туризму», «Школа безопасности» и «Первая помощь».

Экскурсия «Бульварное кольцо: искусствоведческое бинго»
31 августа в 12:00
Предмет: Искусство (МХК)
Формат: очно
Мы поиграем в искусствоведческое бинго: попробуем найти в центре города памятники, относящиеся к различным архитектурным стилям.

Пробная олимпиада по географии
24 августа с 11:30
Предмет: География
Формат: очно и онлайн
Принять участие в пробной олимпиаде можно очно и в онлайн-формате. Победителей и призёров пробной олимпиады ждут призы!

Экскурсия в Т-Банк
21 августа в 17:00
Предмет: Английский язык, Информатика, Искусство (МХК), История, Литература, Математика, Обществознание, Право, Русский язык, Физика, Экономика
Формат: очно
Мероприятие подойдёт и технарям, и гуманитариям — всем, кто думает о карьере в крупном бизнесе.

Турнир по олимпиадой математике для 5–7 классов
19 августа в 10:00
Предмет: Математика
Формат: онлайн
Турнир поможет юным математикам плавно перейти от летнего отдыха к интеллектуальным свершениям.

Интеллектуальная игра «Бункер» с уклоном в ОБЗР
14 августа в 15:00
Предмет: ОБЗР
Формат: онлайн
В ходе игры мы разберём такие темы, как «Чрезвычайные ситуации», «Оказание первой помощи» и «Выживание».

«Персеиды. Мастер-класс по загадыванию желаний и другим важным вещам»
10 августа в 15:00
Предмет: Астрономия
Формат: очно
После мастер-класса вы научитесь определять длину метеора, его яркость, продолжительность и многое другое.

Лекция «Всё самое интересное и секретное о средствах защиты»
4 августа в 15:00
Предмет: ОБЗР
Формат: онлайн
Вы узнаете больше о средствах индивидуальной защиты и посмотрите, как правильно надевать противогаз.

Открытая лекция «Почему астрономы не смотрят на звезды просто глазами?»
1 августа в 16:00
Предмет: Астрономия
Формат: очно
На лекции вы узнаете о принципах работы телескопов, спектрометров и множества других измерительных приборов.

Астрономические наблюдения
31 июля в 17:00
Предмет: Астрономия
Формат: очно
Вы узнаете о принципах работы телескопов, особенностях их строения, посмотрите на статичные объекты и тёмные пятна на Солнце.

Экскурсия «Тайны Тверской улицы: в поисках архитектурных стилей»
19 июля в 12:00
Предмет: Искусство (МХК)
Формат: очно
Экскурсия будет полезна всем, кто хочет научиться определять архитектурные стили и глубже познакомиться с историей и архитектурой Москвы.

Астрономическая викторина о Марсе
12 июля в 14:00
Предмет: Астрономия
Формат: очно
Викторина пройдёт в рамках мероприятия «Неделя Марса» от Музея космонавтики, поэтому рекомендуем посетить их выставку, чтобы лучше подготовиться к игре.

Лекция по ОБЗР о средствах индивидуальной мобильности и практикум по оказанию первой помощи
11 июля в 12:00
Предмет: ОБЗР
Формат: очно
Мы поговорим о нововведениях в сфере ПДД в 2025 году и обсудим, что такое СИМ и какие правила для них существуют.

Открытые лекции от Летней медиашколы АПО
6 июля в 14:30
Предмет: Искусство (МХК), Лингвистика, Литература, Русский язык
Формат: очно
Лекции будут интересны тем, кто хочет научиться точно выражать свои мысли, развивать навыки и будущую карьеру в сфере медиа.

Практическое занятие в планетарии
27 июня в 16:00 и в 17:00
Предмет: Астрономия
Формат: очно
Вы сможете своими глазами увидеть все самые редкие астрономические события за один день. Следующее прохождение Венеры по диску Солнца будет только в 2117 году!

Астрономические наблюдения в Музее космонавтики
12 июня в 12:00
Предмет: Астрономия
Формат: очно
Вы узнаете о принципах работы телескопов, особенностях их строения, посмотрите на статичные объекты и тёмные пятна на Солнце.

Экскурсия-медитация по городку писателей Переделкино
10 июня с 14:00
Предмет: История искусств, Литература
Формат: очно
Будем не только слушать истории о судьбе поэтов и писателей, но и попытаемся представить их стихотворения через телесные, визуальные и медитативные образы.

Конкурс по географии
с 9 по 13 июня
Предмет: География
Формат: онлайн
Мы подведем итоги и выберем участников, набравших больше всего баллов. Приоритет будет у участников, приславших ответы раньше других.

Лекция «Как взвесить чёрную дыру?»
6 июня в 17:00
Предмет: Астрономия
Формат: онлайн
Вы узнаете о международной карьере преподавательницы АПО и исследовании чёрных дыр промежуточных масс.

Международная выставка «Лаоцин: линия поколений сквозь призму китайской живописи»
1–15 июня
Предмет: Искусство (МХК), Китайский язык
Формат: очно
Наши художники обращаются к теме традиционной китайской живописи, выполняя уникальные сюжеты в техниках сеи и гунби.

Экскурсия в Зоологический музей МГУ
25 мая в 11:00 или 13:00
Предмет: Биология, Экология
Формат: очно
Участников также ждёт небольшая лекция о филогенезе позвоночных животных и разнообразии класса млекопитающие.

Астрономические наблюдения
25 мая в 12:00
Предмет: Астрономия
Формат: очно
Вы сможете узнать о принципах работы телескопов, особенностях их строения, а также посмотреть на статичные объекты и пронаблюдать тёмные пятна на Солнце.

Интеллектуальный турнир по олимпиадой математике для 5–7 классов
24 мая в 10:00
Предмет: Математика
Формат: онлайн
Участников ждут захватывающие задачи и возможность посоревноваться с ребятами из разных городов нашей страны.

День химии
24 мая в 12:00
Предмет: Химия
Формат: очно
День химии — это не просто мероприятие, это возможность взглянуть на предмет под разными углами. В этом году участников будет ждать обширная программа!

ИИЛИИ-фест
24 мая 12:00
Предмет: Искусство (МХК), Лингвистика, Литература, Русский язык
Формат: очно
Большое событие, посвящённое цифровой гуманитаристике и тому, какое место в искусстве, истории и литературе занимают новые технологии.

Открытое мероприятие «Решение задач олимпиадного уровня по экономике»
24 мая с 12:00
Предмет: Экономика
Формат: очно
Участникам будет предложен комплект заданий, вдохновлённых логикой ЕГЭ: чёткая структура, ограниченное время и разнообразные типы вопросов.

Лекция «Типы рыночных структур»
23 мая в 17:00
Предмет: Экономика
Формат: онлайн
Участники познакомятся с совершенной конкуренцией, монополией, олигополией и монополистической конкуренцией.

Квиз юб.ил.ейный: писатели-юбиляры в 2025
23 мая в 17:00
Предмет: Литература
Формат: очно
На квизе у участников будет возможность в увлекательной форме повторить важные детали биографии и особенности творчества писателей-юбиляров 2025 года

Майский квиз по физике
23 мая в 16:30
Предмет: Физика
Формат: очно
Участие в квизе командное — от 2 до 6 человек. Вместе с участниками на квиз также может прийти сопровождающий педагог или родитель.

Культурно-просветительское мероприятие «Как богатеет Арабский Восток»
20 мая в 15:40
Предмет: Арабский язык, Международные отношения
Формат: очно
На мероприятии участники узнают об экономической модели стран Арабского Востока, исламском банкинге, методах ведения бизнеса в арабских странах и многом другом.

Лекция «Английская монархия: история через песни»
17 мая в 12:00
Предмет: Английский язык
Формат: онлайн
Вебинар пройдёт на русском языке — приглашаем как олимпиадников по английскому, так и всех, кому интересна история Великобритании.

Основные теории международных отношений в олимпиадах по обществознанию
15 мая в 19:00
Предмет: Обществознание
Формат: онлайн
Лекция будет полезной для учеников 9–11 классов, которые хотят участвовать в «Высшей пробе», других перечневых олимпиадах и ВсОШ.

Фестиваль «Африка с близкого расстояния»
15 мая в 16:00
Предмет: Лингвистика, Международные отношения
Формат: очно
В программе фестиваля — интерактивные лекции и мастер-классы о культуре народов Африки, работа страноведческих павильонов и дегустация традиционной африканской кухни.

Открытая лекция по объектам Мессье
15 мая в 14:00
Предмет: Астрономия
Формат: очно
Мы изучим самые яркие и интересные «лишние» объекты, начиная от Крабовидной туманности и заканчивая галактикой Андромеды.

Интеллектуальная игра по ОБЗР
11 мая в 12:00
Предмет: ОБЗР
Формат: онлайн
После квиза каждый участник получит задания с разбором и объяснениями. Мы разберём ПДД, медицину и первую помощь, ЧС природного характера.

Командный открытый турнир экологов (КОТЭ)
11 мая в 12:00
Предмет: Экология
Формат: очно
Мы приготовили вопросы на разные экологические темы — глобальные экологические проблемы, эволюция и биоразнообразие.

Интерактивная лекция о выборе вуза для участников олимпиад по праву
27 апреля в 14:00
Предмет: Право
Формат: очно
Отличная возможность познакомиться с особенностями юридического образования в ведущих вузах и получить советы от студентов.

Фестиваль «Погружение в исторический источник: основы русской палеографии»
26 апреля с 11:00
Предмет: История
Формат: очно и онлайн
На фестивале вы узнаете про эволюцию письма и почерков в России и практикуетесь в чтении рукописных исторических источников XV, XVII, XVIII веков.

Форум «БРИКС: взгляд в будущее»
24 апреля в 13:00
Предмет: Китайский язык
Формат: очно
Цель форума — познакомить школьников с международной организацией БРИКС, культурой и традициями стран-членов БРИКС, а также заинтересовать научной деятельностью.

Лекция для учителей «Работа со статистическими материалами на уроках истории»
23 апреля в 16:00
Предмет: История
Формат: очно
Занятие будет посвящено тому, какую роль в истории играют точные науки и почему историку важно владеть математическими методами.

Открытая лекция по астрономии
23 апреля в 16:00
Предмет: Астрономия
Формат: очно
Вы узнаете, как использовать своё тело в качестве измерительного прибора, об основных навигационных звёздах и о способах определения долготы.

Лекция «Куда деваются утки зимой? Разбор романа Сэлинджера „Над пропастью во ржи“»
23 апреля в 15:00
Предмет: Английский язык, Лингвистика, Литература
Формат: онлайн
Вместе окунёмся в неоднозначную биографию Сэлинджера, непростой путь (и речь) главного героя и, конечно, ответим на вопрос: «Куда деваются утки зимой?»

Открытый вебинар «Неорганическая химия: решение олимпиадных цепочек»
20 апреля в 16:00
Предмет: Химия
Формат: онлайн
На вебинаре участники обсудят подходы к решению цепочек превращений, разберут подсказки в заданиях и отработают знания на практике.

Игра «Код да Винчи» в День божественных комедий
19 апреля с 13:00
Предмет: Искусство (МХК)
Формат: очно, Олимпийский пр-кт 11с2
Мы вместе отметим завершение ВсОШ этого учебного года, обсудим олимпиадный сезон и отдохнём после месяцев напряжённой подготовки.

Фестиваль «Кирпичики мечты»
19 апреля в 12:30
Предмет: Искусство (МХК), Литература
Формат: очно
Гостей фестиваля ждут мастер-классы, встречи с филологами и культурологами, лекции о подростковой литературе и многое другое.

Интеллектуальная игра по астрономии
17 апреля в 16:00
Предмет: Астрономия
Формат: очно
Участники смогут продемонстрировать свои знания в астрономии и получить призы. Для участия необходимо зарегистрироваться.

Лекция «Дневники и воспоминания: легенда или источник информации для историка-исследователя?»
12 февраля, 19 марта, 16 апреля в 17:00
Предмет: История
Формат: очно
На лекции участники подробно рассмотрят дневники и воспоминания политических деятелей начала XX века. Приглашаем учеников 8–10 классов и учителей истории.

«КосмоКвест: тайна неисправной ракеты» от проекта «Физика ЦПМ»
13 апреля в 11:30
Предмет: Физика
Формат: очно
От юных инженеров потребуется ни много ни мало — спасти экипаж космического судна! По легенде на орбите случилась авария: двигатели отключены и кислород на исходе.

Открытый турнир по географической номенклатуре
Второй тур 12 апреля в 14:00
Предмет: География
Формат: онлайн
Баттл позволит запомнить географические объекты, которые пригодятся не только на школьных уроках, но и на олимпиадах, в том числе на заключительном этапе ВсОШ.

Культурно-образовательное мероприятие «Терракотовая армия как значимый памятник наследия ЮНЕСКО»
3 апреля в 17:00
Предмет: Китайский язык
Формат: очно
На мероприятии участники узнают о культурно-историческом наследии ЮНЕСКО в Китае, истории раскопок гробницы Цинь Шихуанди и смогут поучаствовать в викторине.

Серия мастер-классов по международной журналистике
1 апреля с 16:30
Предмет: Английский язык, Обществознание
Формат: очно
Слушатели узнают, как в этой профессиональной области можно применить углубленные знания обществознания и английского языка.

Открытая лекция «Звёздное небо» в Музее космонавтики
29 марта в 13:00
Предмет: Астрономия
Формат: очно
На лекции мы познакомимся с самыми известными созвездиями, узнаем мифы и легенды о них, а также обсудим, какие из них наиболее интересны астрономам-любителям.

Фестиваль «МиниФизFest»
23 марта с 10:30
Предмет: Физика
Формат: очно
К участию приглашаются ученики 5–6 классов и их родители. На фестивале ребята погрузятся в мир физики и откроют его новые грани.

Вебинар «Подготовка к олимпиадам по экологии разного уровня. Форматы заданий, изменения 2025 года, подготовка»
22 марта в 16:00
Предмет: Экология
На вебинаре вы узнаете структуру олимпиады, главные темы соревнования, особенности проектного тура в 2025 году и многое другое.

Вебинар «Рецепт хорошего всеросса: как победить в олимпиаде по русскому языку»
21 марта в 18:00
Предмет: Русский язык
Формат: онлайн
На вебинаре вы узнаете больше о формате проведения туров и научитесь работать с критериями, а на десерт — Q&A сессия с призёром ВсОШ прошлого года.

Лекция для учителей «Историческая урбанистика на уроках истории: анализ городского пространства»
20 марта в 16:00
Предмет: История
Формат: очно
Занятие будет посвящено изучению урбанистики на уроках истории и анализу городского пространства. Вы получите примеры работы с топонимикой и визуальными источниками.

Вебинар «Подготовка устного выступления на олимпиадах по истории»
15 марта в 16:00
Предмет: История
Формат: онлайн
Вы узнаете о формате устного выступления на основе исторических материалов, научитесь правильно распределять время при подготовке и на самом выступлении.

Открытый вебинар «Реакции конденсации органических веществ в химических задачах»
15 марта в 15:00
Предмет: Химия
Формат: онлайн
На вебинаре мы детально обсудим основные реакции конденсации в органической химии, разберёмся в сложностях, решим тематические задания.

Открытая лекция «Зодиакальные созвездия» в Музее космонавтики
13 марта в 17:00
Предмет: Астрономия
Формат: очно
Мы поговорим о зодиакальных созвездиях, их настоящем влиянии на историю развития человечества, условиях наблюдения, основных мифах и легендах, связанных с ними.

Вебинар «Низкоуровневые оптимизации» в двух частях
10 и 11 марта в 17:00
Предмет: Информатика
Формат: онлайн
Как получать более высокие баллы за, казалось бы, неоптимальные алгоритмы? Вебинар будет полезен и начинающим, и опытным олимпиадникам.

Открытая лекция-практикум «Ich Kann(t): о трансцендентном идеализме простыми словами. Часть II»
8 марта в 18:00
Предмет: Немецкий язык
Формат: онлайн
Мы, кратко обновив знания предыдущих разделов, дополним их беседой об эстетике Канта, его философии политики, а также поговорим об отношениях Канта с Россией.

Вебинар «Подготовка устного выступления на олимпиадах: что и как говорить?»
8 марта в 18:00
Предмет: Обществознание
Формат: онлайн
На вебинаре мы поговорим об особенностях оценивания устного тура, разберём стратегии подготовки выступления и структуру ответа.

Открытая лекция-практикум «Der doppelte Kästner: часть II»
7 марта в 18:00
Предмет: Немецкий язык
Формат: онлайн
На лекции мы обсудим не слишком широко известные произведения Кестнера, поговорим о многочисленных экранизациях его произведений и отношениях с кинематографом.

Дистанционный конкурс «КиноИстория»
22–23 февраля
Предмет: История
Формат: онлайн
В кино может отражаться прошлое, настоящее или их восприятие современниками. А умение анализировать кино как исторический источник — важный навык современного историка.

Зимний турнир юных математиков
22 февраля в 10:00
Предмет: Математика
Формат: онлайн
Турнир — это отличная возможность потренироваться перед заключительными этапами олимпиад и познакомиться с ещё одним видом математической игры.

Вебинар «Олимпиадная история искусств»
21 февраля
Предмет: Искусство (МХК)
Формат: онлайн
Перед заключительным этапом ВсОШ по МХК преподаватели будут отвечать на вопросы о художниках-юбилярах, актуальных актёрах и не только.

Лекция «Культура и быт Северной Кореи»
20 февраля в 17:30
Предмет: Китайский язык
Формат: онлайн
На лекции участники узнают о культурных особенностях, быте, традициях и обычаях северокорейского народа и ещё много нового о жизни одной из самых закрытых стран мира.

Вебинар «Нетипичные задачи перечневых олимпиад»
15 февраля в 15:00
Предмет: Химия
Формат: онлайн
На вебинаре участники разберутся в смежных темах из физики и биологии, полезных при решении таких задач и не только.

Вебинар «Кинолента прошлого: как историку работать с киноматериалами»
14 февраля в 17:00
Предмет: История
Формат: онлайн
Историку важно уметь смотреть кино не только как художественное произведение, но и видеть в нём исторический источник, и знать, как с помощью видео заглянуть в прошлое.

Фестиваль «Традиции празднования Нового года в странах Востока»
29 января в 16:30
Предмет: Китайский язык
Формат: очно
Большое лингвострановедческое путешествие по Востоку. Мастер-классы, лекции и интерактивные площадки по традициям встречи Нового года у разных народов Азии и Африки.

Интерактивная лекция «Конфуцианский Китай: путешествие в провинцию Шаньдун»
21 января в 16:30
Предмет: Китайский язык
Формат: очно
На лекции слушатели узнают о достопримечательностях провинции Шаньдун, родных местах Конфуция и священной вершине Поднебесной — горе Тайшань.